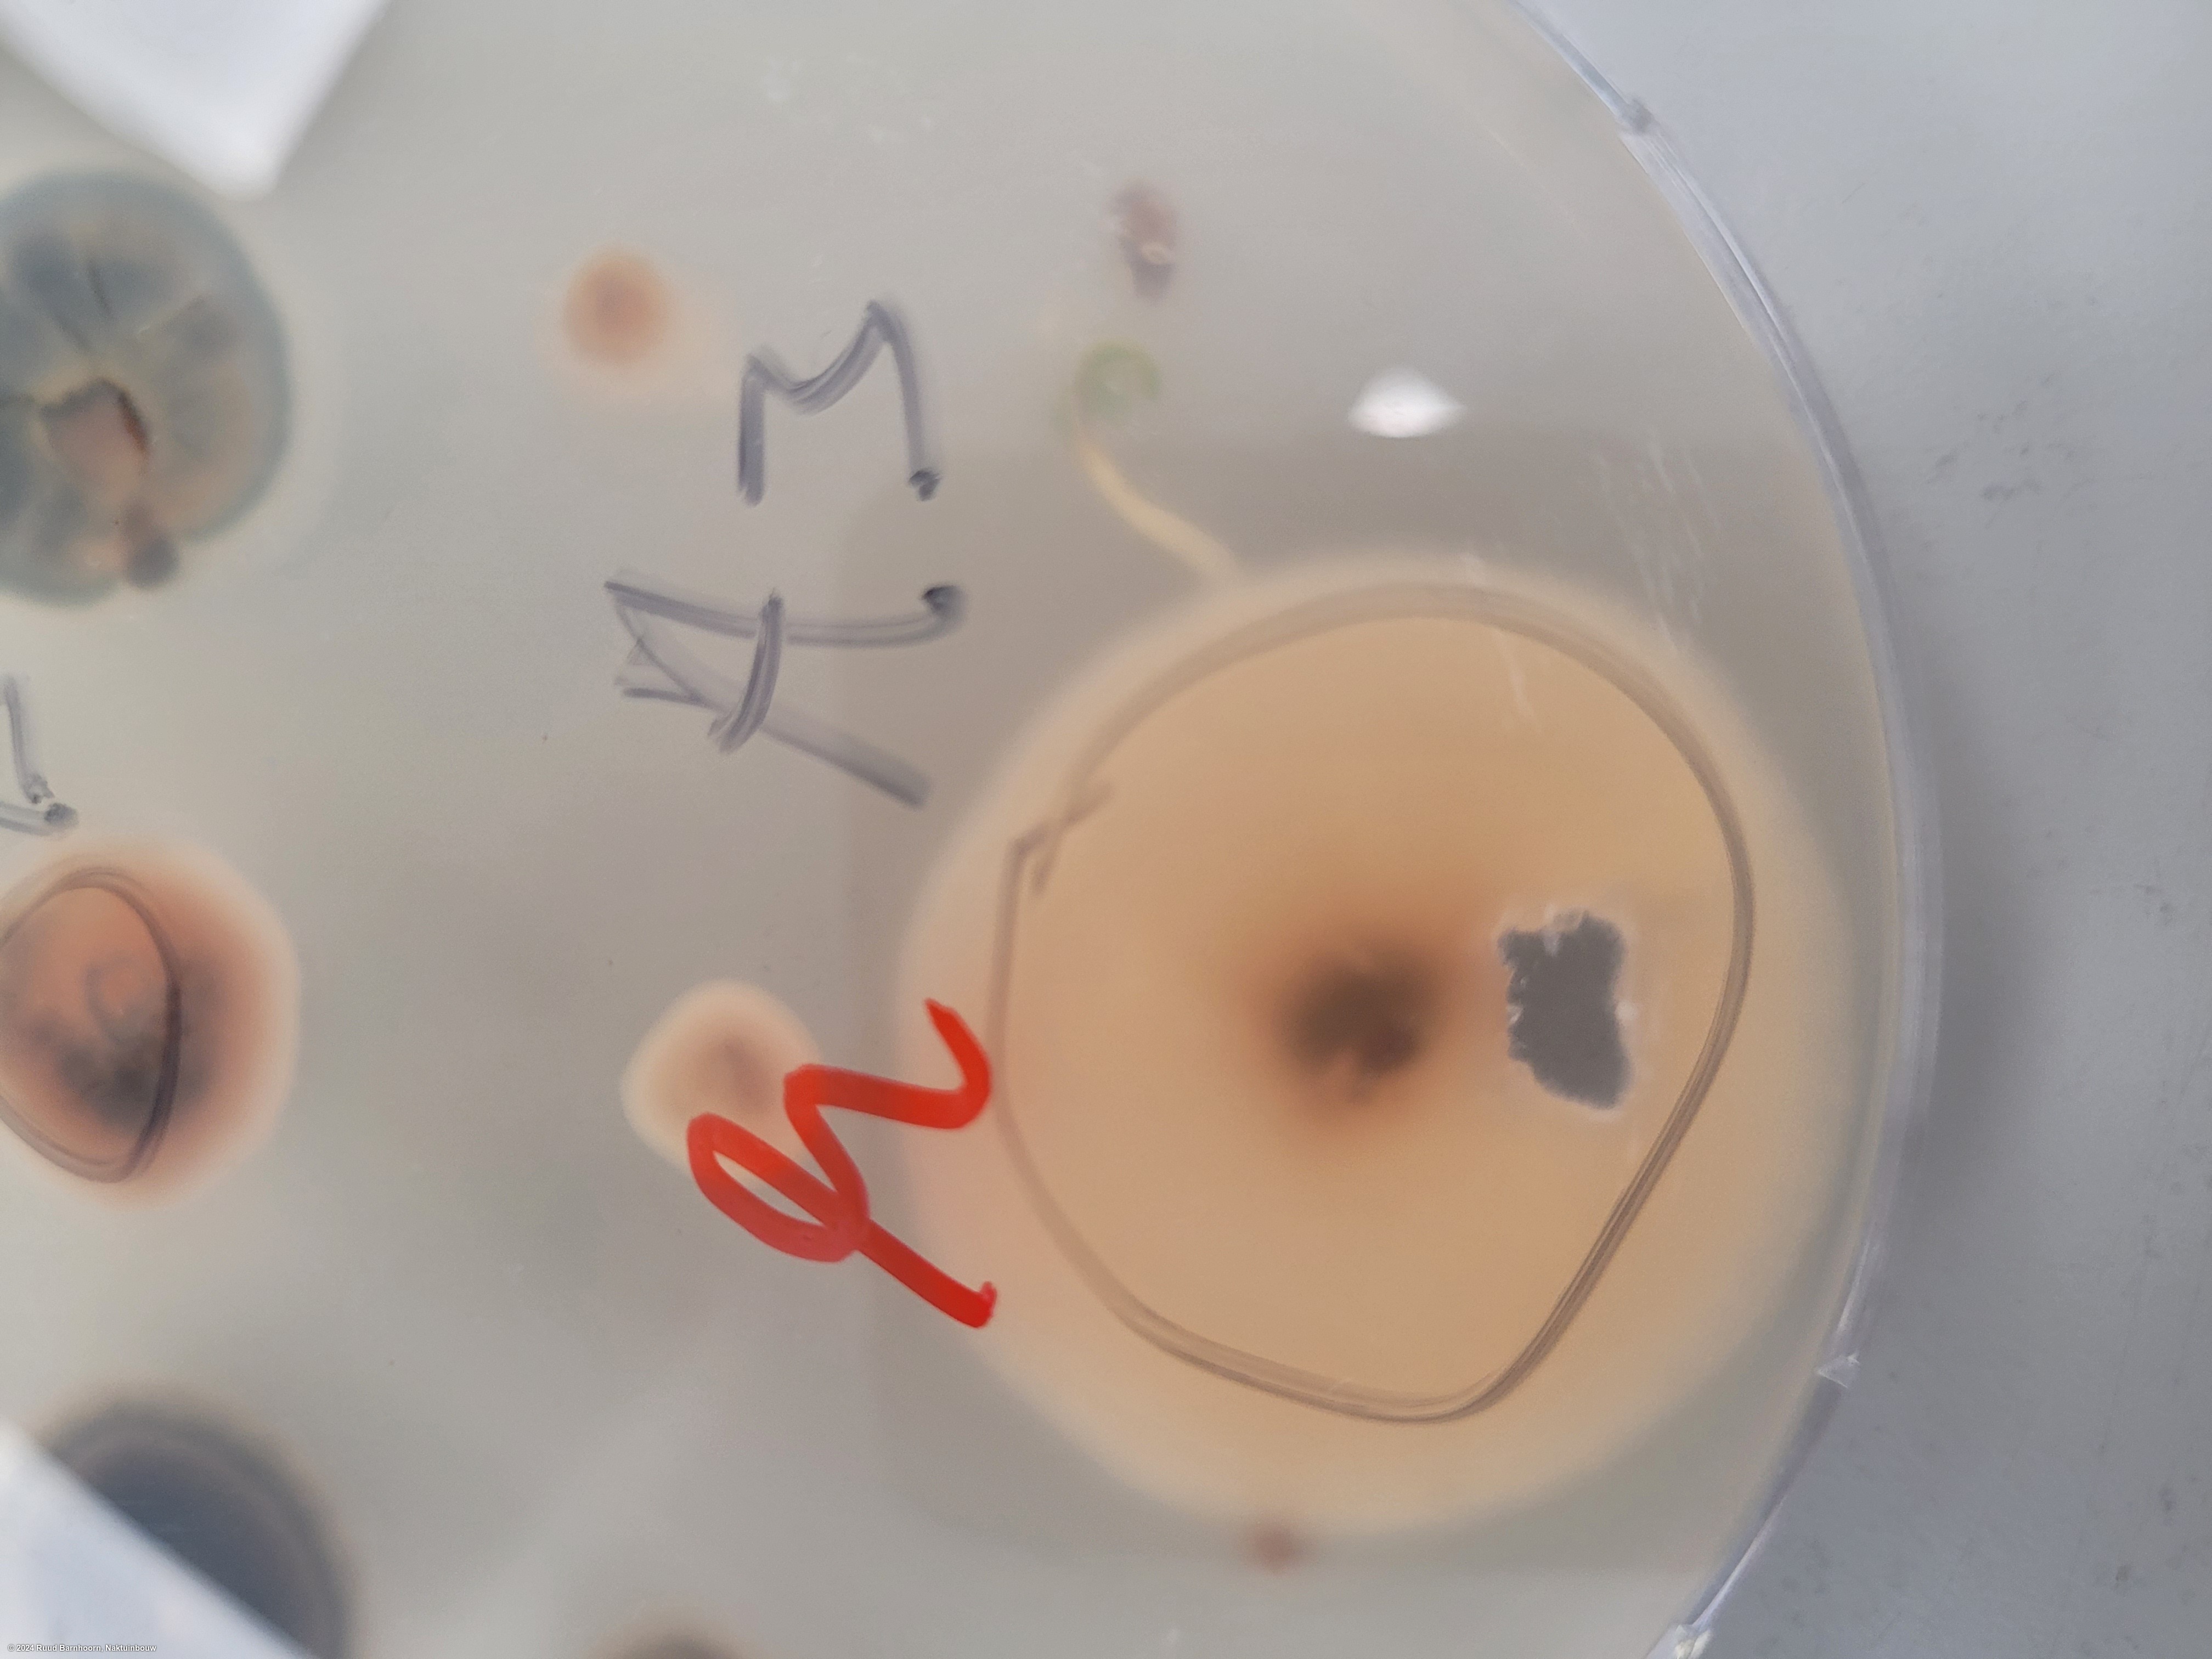
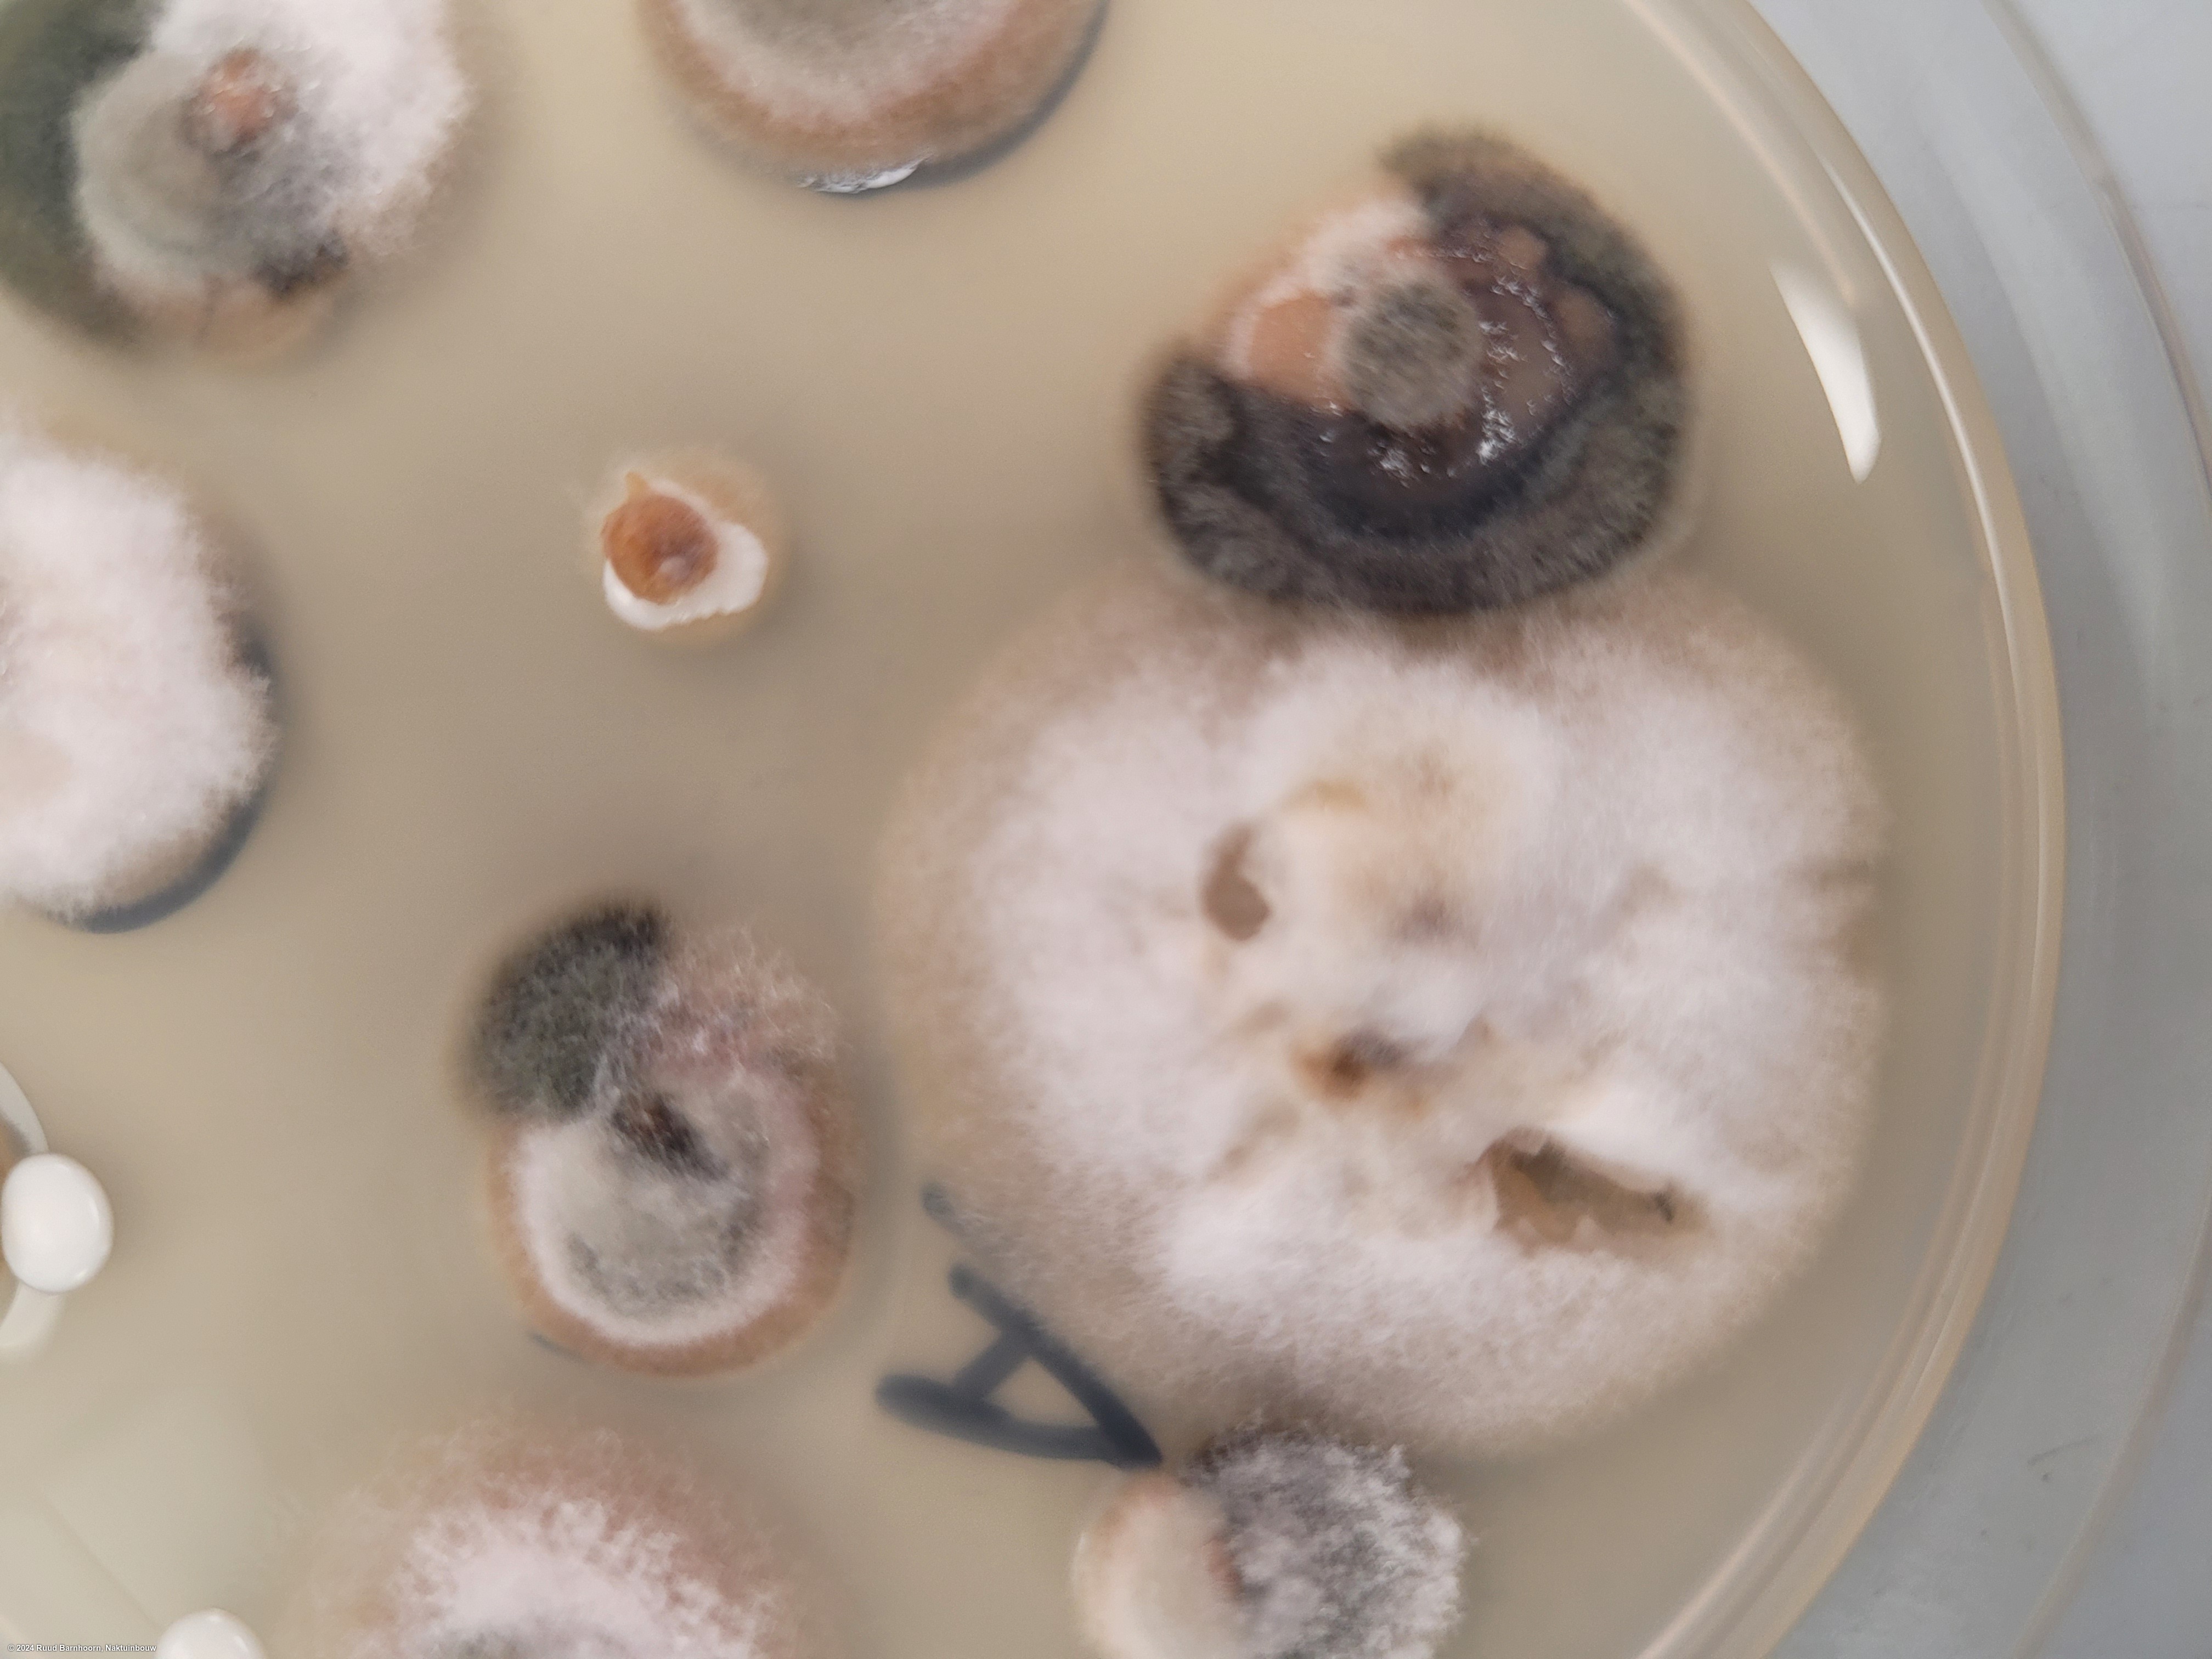
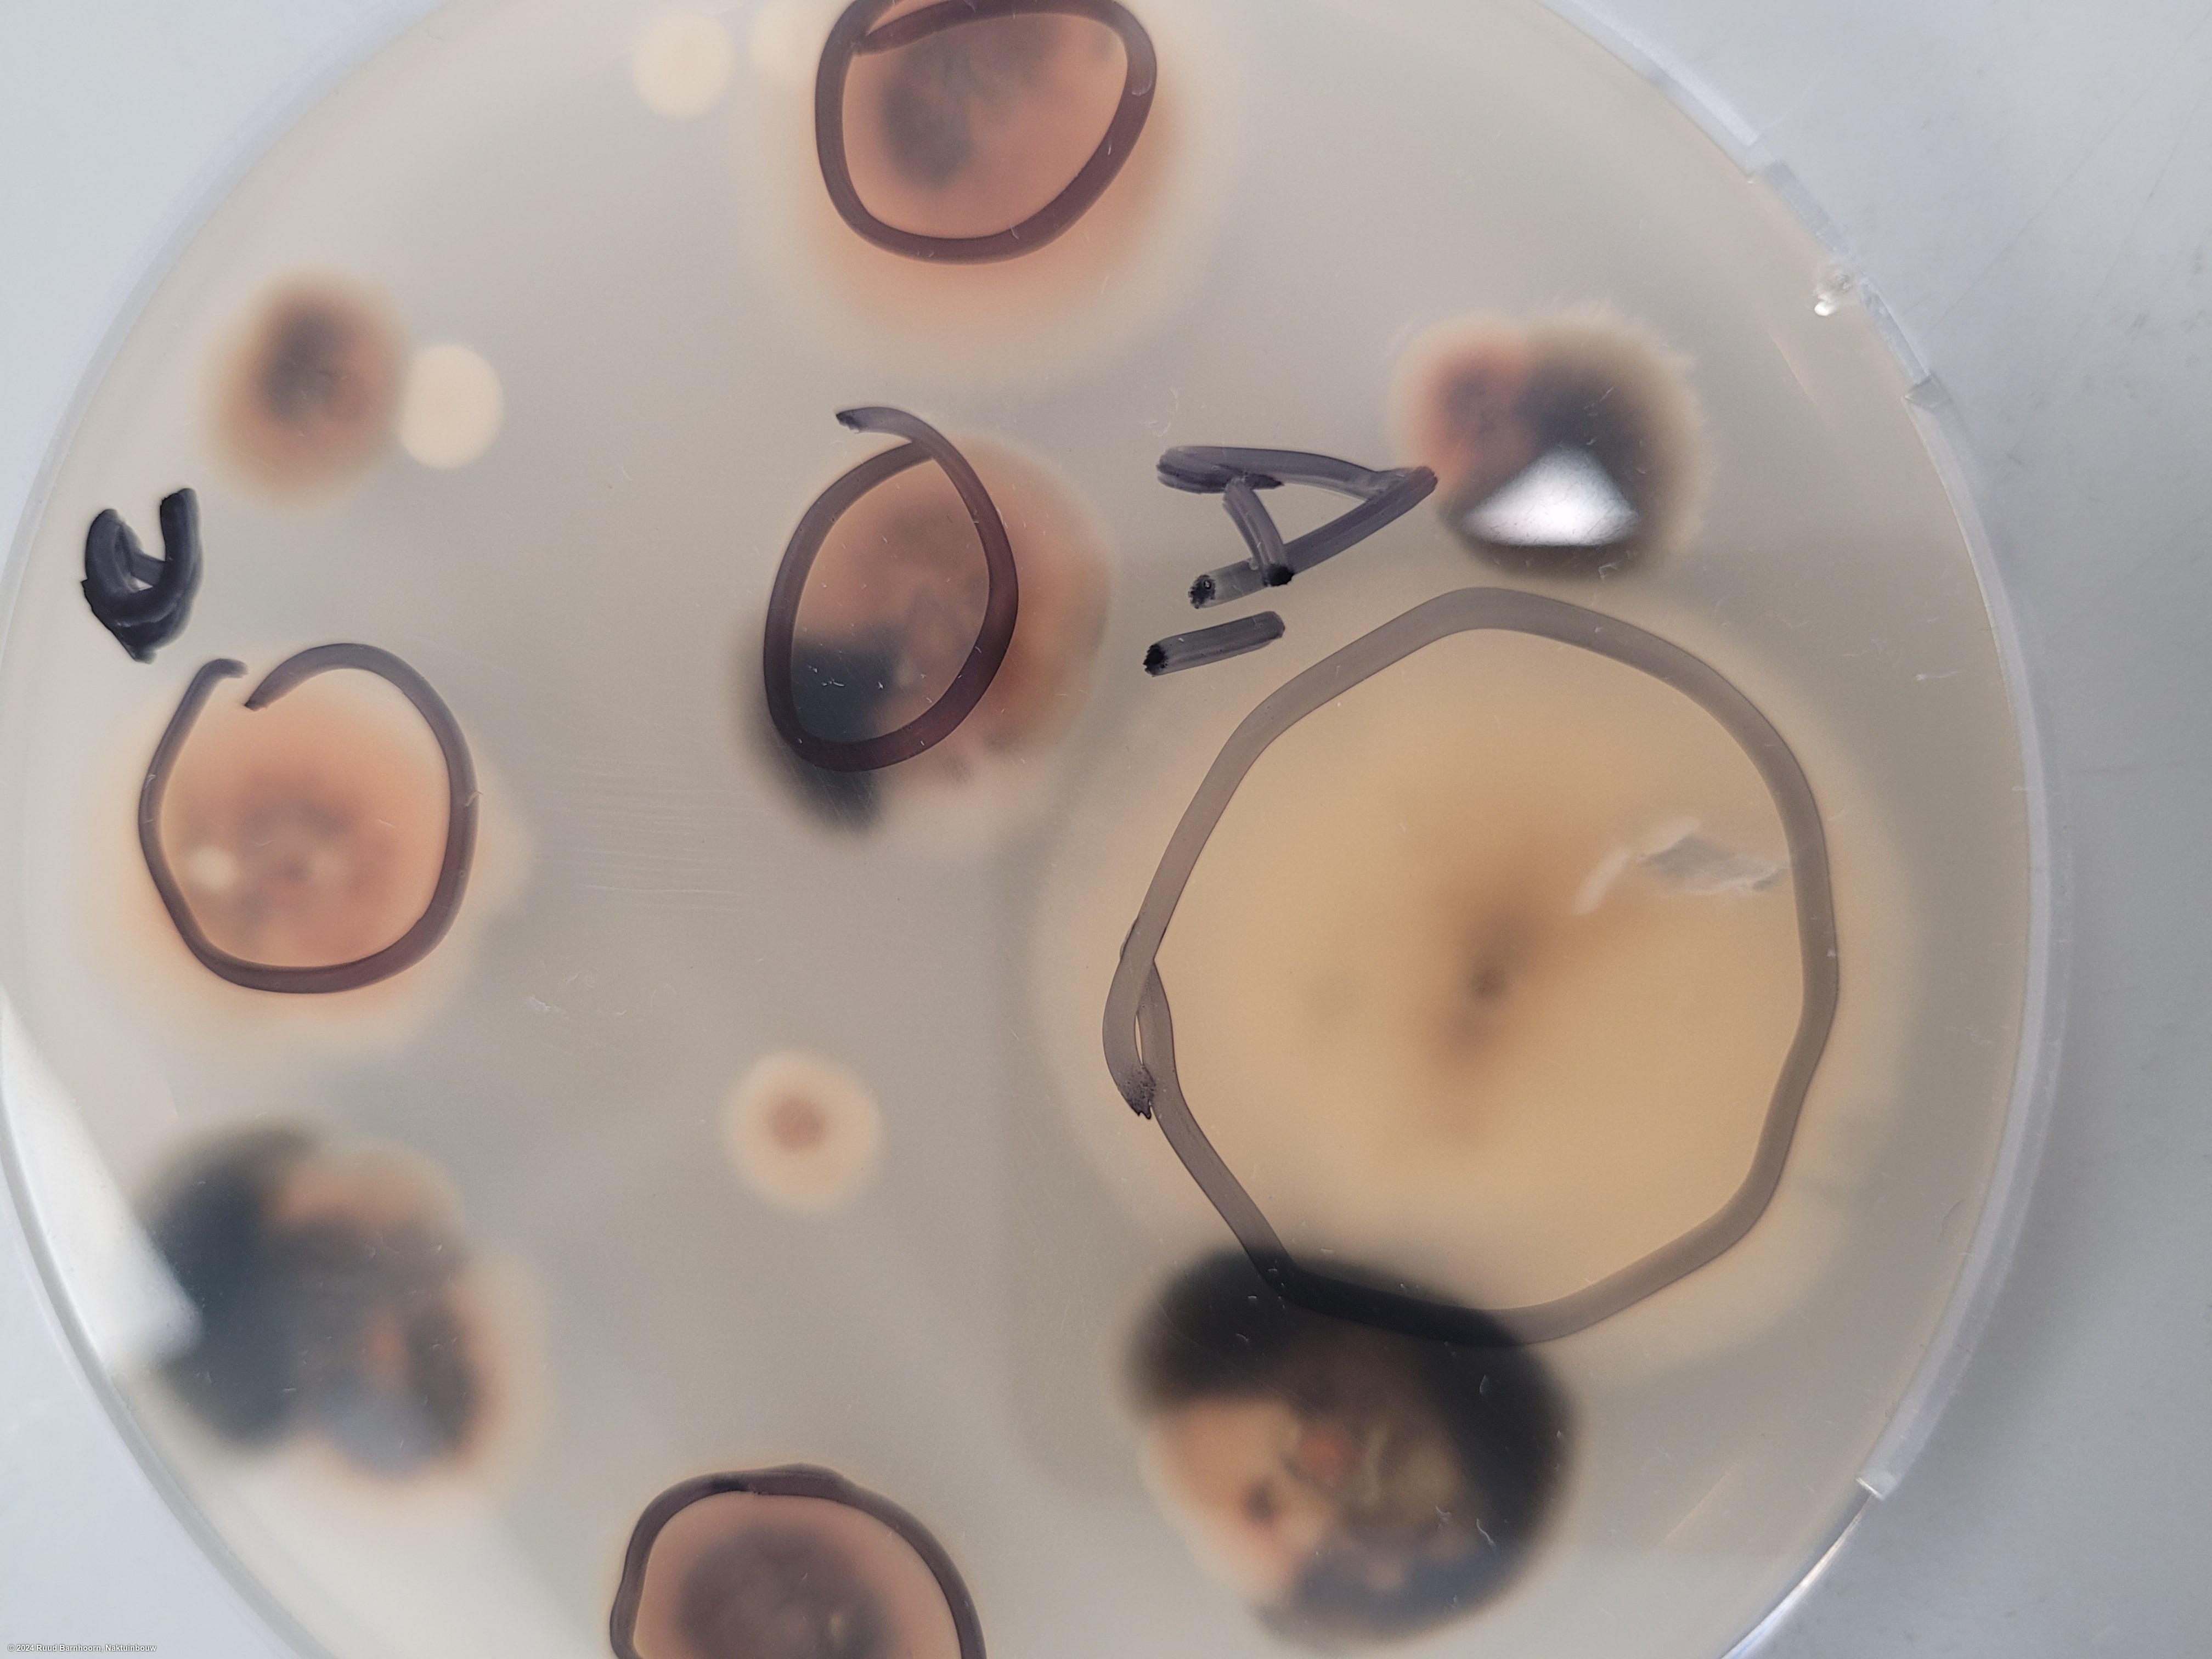
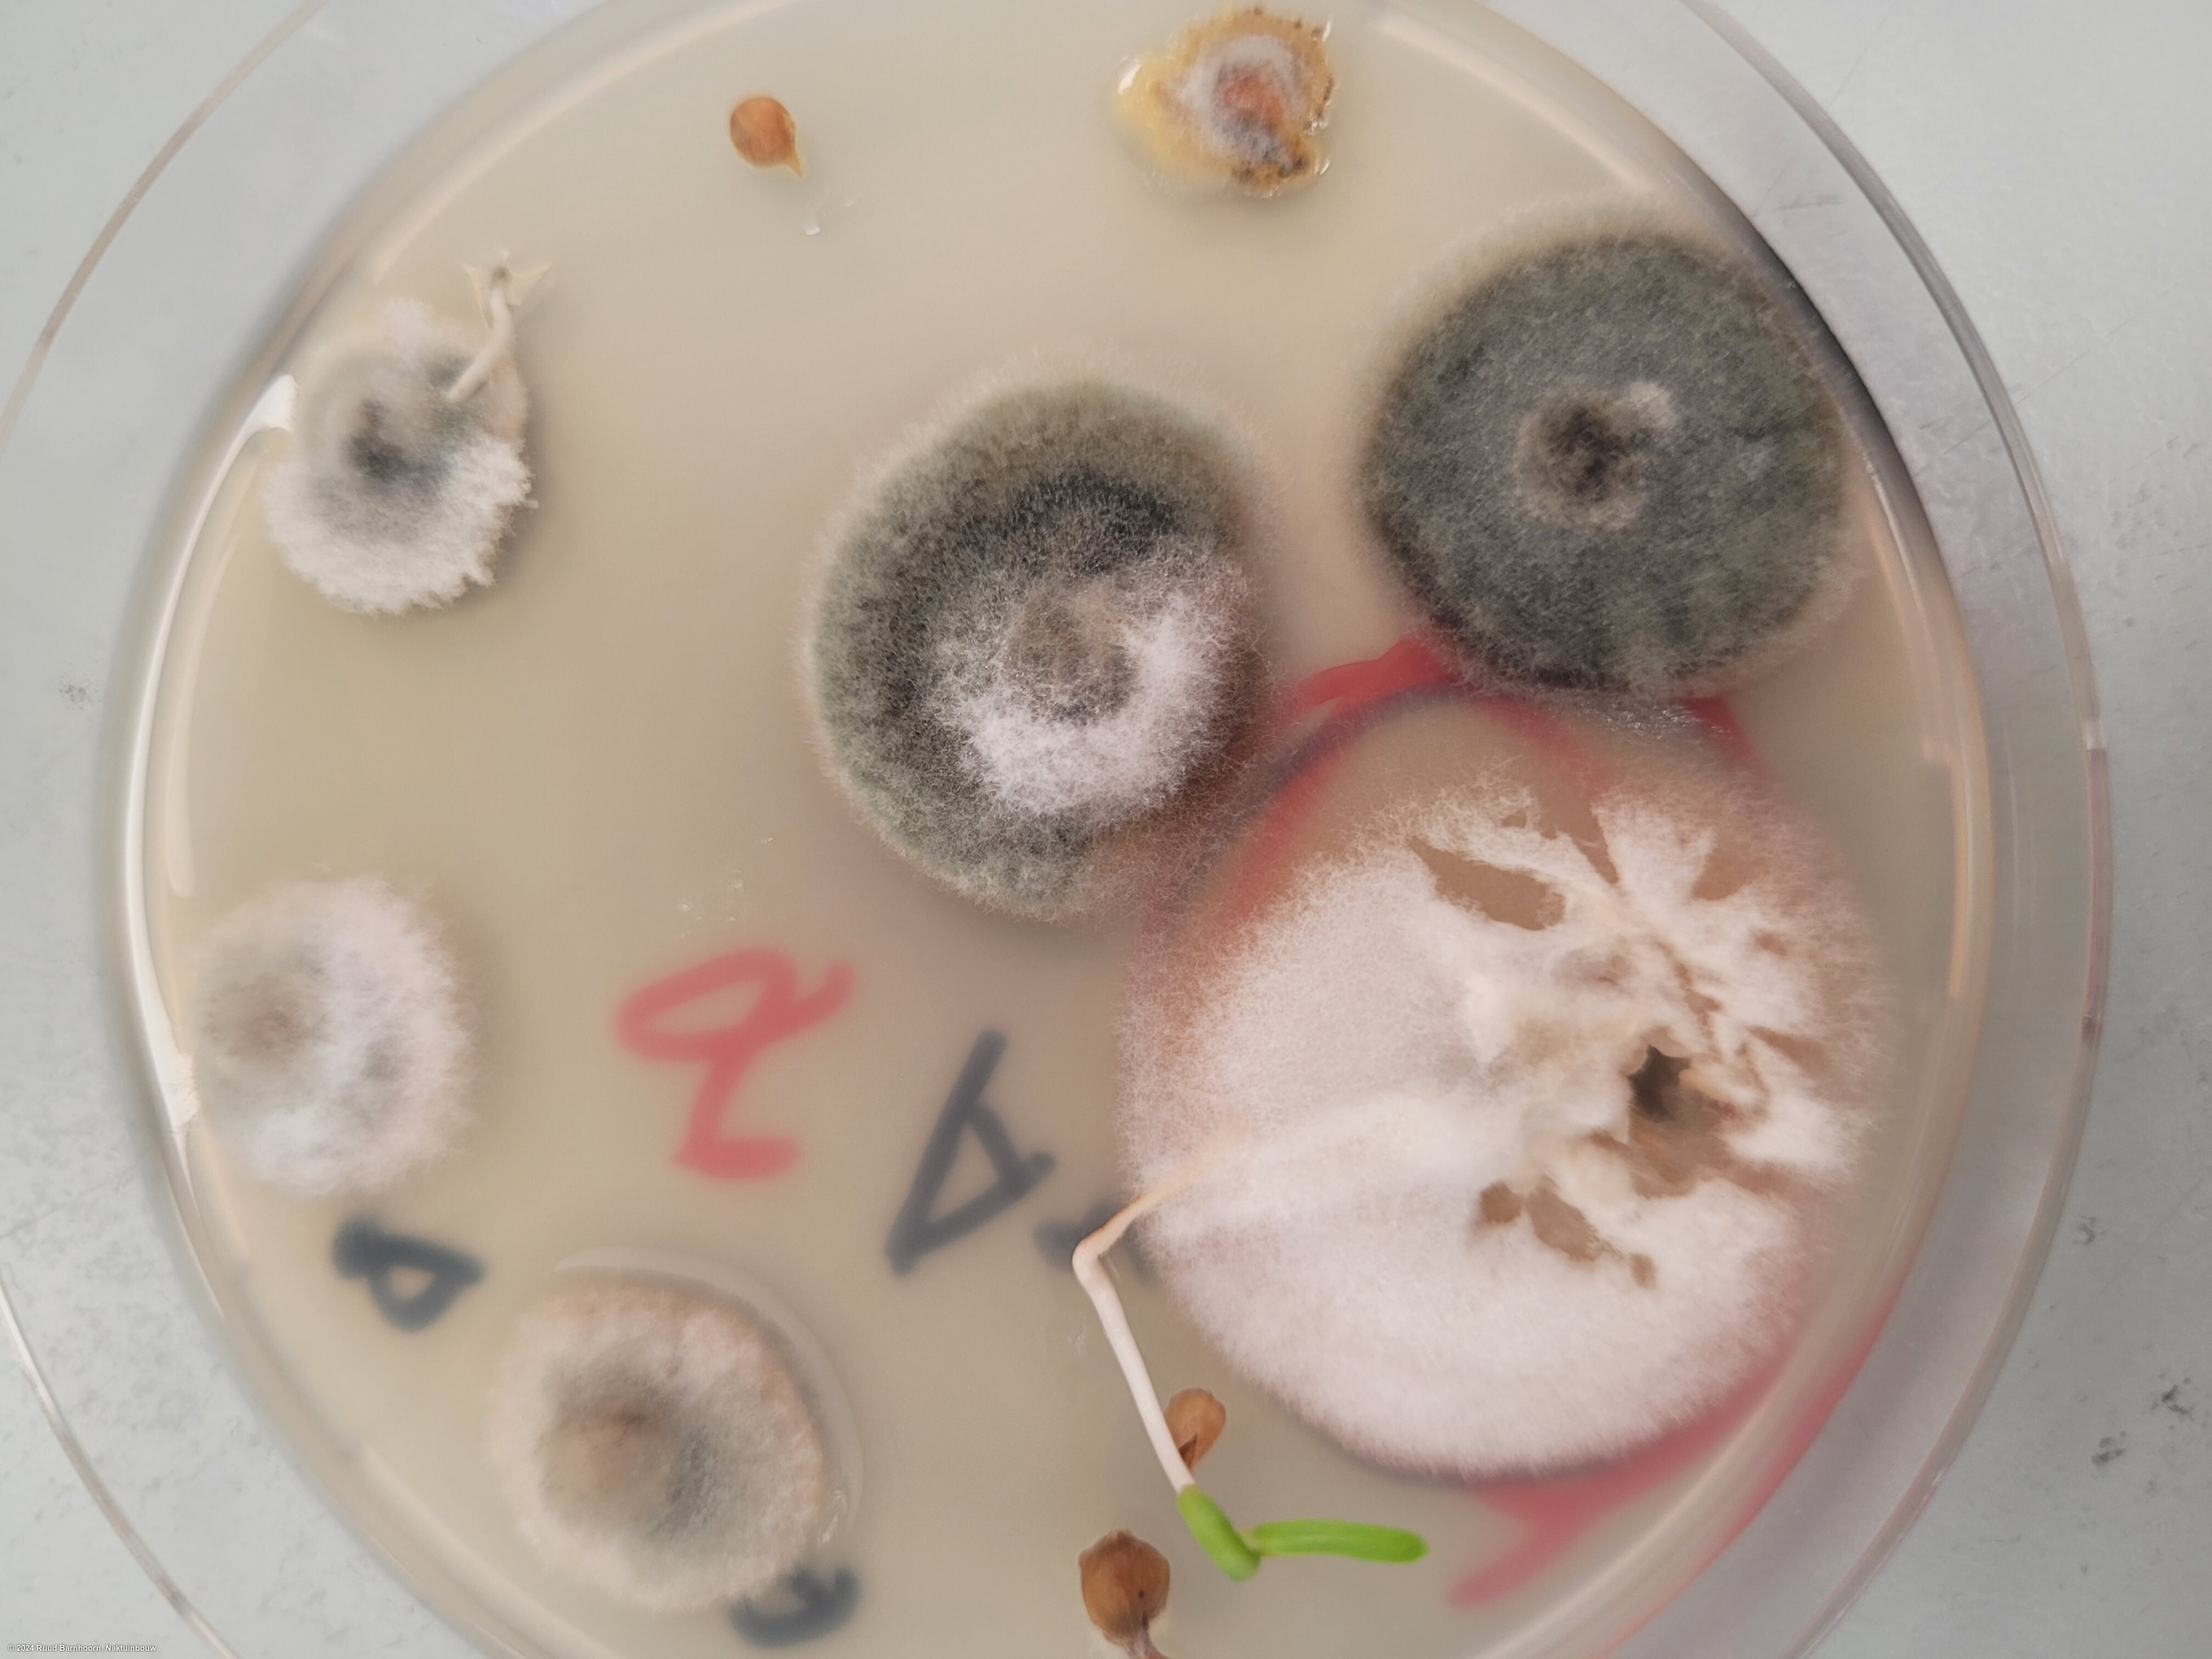

Submission
Fusarium oxysporum on Spinacia oleracea
- Credits / Owner: Ruud Barnhoorn, Naktuinbouw
- Submission date: 2024-06-20 15:49:33
- Submission ID: #6
Pathogen
|
Scientific name
|
Fusarium oxysporum |
|
Genus
|
Fusarium |
|
EPPO code
|
FUSAOX |
|
Common name
|
Fusarium Wilt |
|
Synonyms
|
Cylindrophora albedinis |
|
Crop
|
Spinacia oleracea |
Submission
Description
The image shows inblack circles, white /pink fluffy F.o. spinacea colonies.
| Sterilant: | 1% NaOCL-oplossing |
| Sterilant time: | 1 minute |
| Growth time: | 5 days |
| Lighting: | darkness |
| Agar: | PDA + streptomycin |
| Agar brand: | Millipore (Merck) |
| Sample origin: | Netherlands |